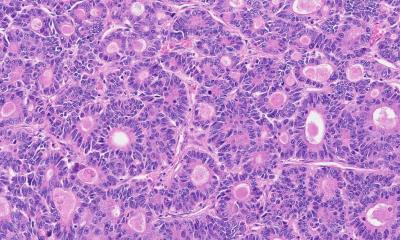
Photo

News • Swiss national study reveals
Colorectal cancer on the rise among people under 50
The incidence of colorectal cancer is rising among younger individuals, sometimes as early as their thirties. The research also shows the challenge of late diagnoses and calls for increased awareness.